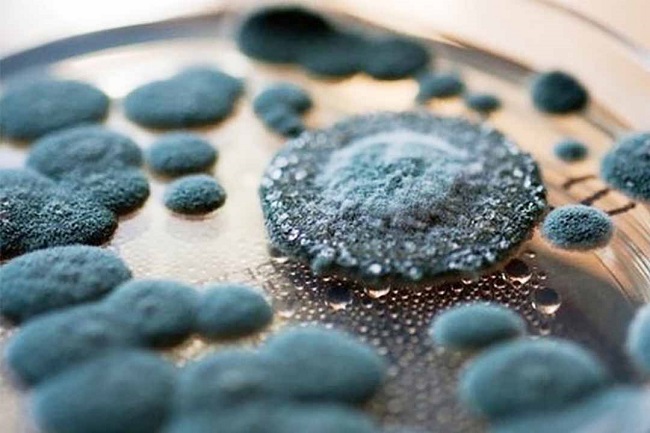
nam moc den gay hai suc khoe

Cách loại bỏ nấm mốc đen
Để xử lí triệt để nấm mốc đen, chúng ta cần tìm hiểu chi tiết về loại nấm này cũng như các tác hại mà chúng gây ra.
Nấm mốc đen là loại nấm được sinh ra trong môi trường ẩm ướt, chúng là loại sinh vật có chân hạch và cấu tạo từ những tế bào chứa diệp lục. Loại nấm mốc đen thường sống kí sinh trên các vách tế bào được hình thành từ chitin. Thông thường chúng sẽ cấu tạo hình sợi và phát triển dưới dạng đơn bào. Bạn có thể dễ dàng thấy chúng ở những nơi ẩm ướt như nhà tắm hoặc gian bếp.
Nấm mốc đen gây những tác hại khôn lường và nghiêm trọng. Nấm mốc đen sẽ tạo ra hợp chất độc hại có tên gọi là mycotoxin. Chúng sẽ gây nên những vấn nghiêm trọng về sức khỏe như khó thở, dị ứng, viêm, mệt mỏi hay nhiễm trùng xoang mãn tính, ức chế hệ thống miễn dịch của cơ thể và làm tổn thương các cơ quan trong nội tạng.
Nấm mốc đen gây hại nghiêm trọng cho sức khỏe
Bên cạnh đó, nếu để chúng bám vào tường lâu dài sẽ phá vỡ kết cấu ngôi nhà và hư hỏng tường. Không thể cứu chữa. Chúng còn khiến ngôi nhà của bạn mất thẩm mỹ, trở nên xấu xí. Tốn chi phí sửa chữa về vật chất lẫn đời sống sức khỏe.
Khi bạn phát hiện ra những mảng nấm mốc đen xuất hiện trong nhà tấm và gian bếp thì bạn cần loại trừ chúng một cách nhanh chóng để đảm bảo sức khỏe cho các thành viên trong gia đình. Với những nguyên liệu quen thuộc sau đây sẽ giúp bạn loại trừ nấm mốc đen gây hại
Oxy lỏng hay còn gọi là H2O2, đây là một loại dung dịch chống nấm, kháng vi rút cũng như loại trừ vi khuẩn hiệu quả. Bạn có thể tìm mua chúng ở các tiệm thuốc uy tín. Với đặc tính bảo vệ an toàn cao trong quá trình sử dụng nên bạn có thể thoải mái sử dụng trên bề mặt các thiết bị nhà bếp và quầy, vật dụng trong phòng tắm và bồn tắm.
Bạn chỉ cần đổ dung dịch H2O2 với nồng độ 3% vào bình xịt, sau đó xịt dung dịch này vào những chỗ bị mốc và để yên trong 10 phút. Sau đó, bạn nhẹ nhàng chà rửa lại để loại bỏ nấm mốc đen, sau khi đã loại bỏ hoàn toàn nấm độc hại này bạn tiến hành lau khô lại là hoàn tất.
>> Xem thêm: Thông bồn rửa chén Quận Phú Nhuận cam kết uy tín, chất lượng tốt
Giấm là nguyên liệu dễ dàng tìm thấy trong gian bếp và trợ thủ cừ khôi trong các công trình tẩy rửa, làm sạch. Trong giấm có tính axit nhẹ giúp chúng khử trùng, khử mùi hiệu quả. Giấm có thể diệt trừ đến 82% các loại nấm mốc, trong đó có cả nấm mốc đen. Cách thực hiện rất đơn giản như sau:

Dùng giấm loại trừ nấm mốc đen
Bạn đổ giấm vào bình xịt và không nên pha loãng nó với nước. Sở dĩ trong giấm chỉ chứa 20% axit axetic nên nếu pha loãng sẽ làm giảm tác dụng của giấm. Bạn sẽ xịt dung dịch giấm vào các vị trí bị nấm mốc đen và để yên chúng trong 1 giờ để hoạt chất trong giấm ngấm vào giúp loại trừ nấm mốc đen. Sau đó bạn chỉ cần lau sạch lại với nước và đẻ khô bề mặt tự nhiên.
Baking Soda cũng đem đến hiệu quả loại trừ nấm mốc đen đáng kinh ngạc. Bên cạnh đó sản phẩm này đảm bảo an toàn cho sức khỏe các thành viên trong gia đình và thú cưng. Nếu như nhà bạn đang có sẵn baking soda thì có thể áp dụng ngay cách sau đây.
Sử dụng ¼ muỗng bột baking soda cho vào bình xịt có chứa nước, sau đó lắc đều đến khi tan hết. Bạn xịt dung dịch này vào đang có nấm mốc đen, sao đó dùng bàn chải chà sạch để loại bỏ nấm mốc đen trên bề mặt. Tiếp đến bạn dùng nước để rửa sạch lại nhằm loại bỏ cặn bẩn. Cuối cùng bạn xịt tiếp dung dịch vào khu vực bị nấm mốc đen để ngăn ngừa chúng quay trở lại.
Trong chanh chứa nồng độ axit cao giúp loại bỏ hoàn toàn nấm mốc đen một cách tự nhiên và an toàn.

Trị nấm mốc đen bằng chanh
Bạn chỉ cần lấy nước cốt của 3 - 5 quả chanh và đổ lên khu vực bị nấm mốc. Sau đó để yên trong 5 phút và lau sạch bề mặt bằng khăn ẩm.
Ngăn chặn nguồn ẩm
Nguyên nhân nấm mốc đen xuất hiện tại nhà vệ sinh và gian bếp là do 2 khu vực này thường xuyên ẩm ướt. Vì vậy, bạn nên hạn chế nguồn nước không để chảy đến 2 khu vực này. Bên cạnh đó, bạn cần vệ sinh bồn rửa và nhà tắm hàng ngày để ngăn ngừa sự sản sinh của nấm mốc đen.
Phong tỏa khu vực bị nấm mốc
Khi phát hiện khu vực xuất hiện nấm mốc đen, bạn có thể tạm thời bịt kín khu vực bị mốc đen bằng cách dán một tấm nhựa lên cửa. Sau đó, nhanh chóng tiến hành các giải pháp xử lí nấm mốc đen để chúng không lan ra các vùng khác.
Làm sạch một cách an toàn
Trong quá trình làm sạch nấm mốc đen. bạn nên đeo khẩu trang để ngăn ngừa việc hít phải các bào tử nấm mốc độc hại. Để đảm bảo an toàn tuyệt đối bạn có thẻ sử dụng thêm quần áo bảo hộ dùng 1 lần và quần áo sau khi tiếp xúc với nấm mốc đen cần giặt lại bằng nước nóng.
Bạn cũng cần sử dụng các hóa chất đúng và chất lượng để làm sạch triệt để nấm mốc đen, hạn chế tối đa việc chúng phát sinh trở lại trong thời gian ngắn.
Sau khi đã vệ sinh xong nấm mốc đen, bạn cần đặt các vật dụng làm sạch, đồ bảo hộ vào trong một túi kín để các bào tử nấm mốc không có cơ hội di chuyển sang các khu vực khác.

Vứt bỏ dụng cụ làm sạch đúng nơi, đúng cách
Còn nếu như bạn muốn tái sử dụng lại những vật dụng này thì cần giặt và khử khuẩn chúng sạch sẽ sau đó đem đi phơi dưới ánh nắng mới được sử dụng lại.
Giữ cho vải và các bề mặt trong nhà luôn khô ráo
Những nơi ẩm thấp chính là nơi ở lí tưởng cho nấm mốc đen. Vì thế bạn cần giữ quàn áo, giày hoặc khăn ướt cẩn thận, không được gom thành đống trong nhà tắm, vì đây chính là nơi hoàn hảo để nấm mốc bám vào .
Bạn cần treo những món đồ ướt ở ngoài trời để hong khô chúng nhanh hơn. Ngoài ra, sau khu tắm rửa, vệ sinh, bạn cần lau khô các ngăn và bồn tắm bằng chổi cao su để đảm bảo thông thoáng.
>> Xem thêm: Thông bồn rửa chén Quận Gò Vấp giá cả ưu đãi, bảo hành lâu
Gia tăng sự thông gió trong ngôi nhà
Bạn có thể trang bị thêm quạt trần hoặc quạt tuần hoàn để giúp loại trừ độ ẩm cao. Chúng sẽ giúp bạn hong khô phòng tắm và gian bếp nhanh hơn, loại bỏ hoàn toàn hơi nước. Bên cạnh đó, bạn có thể mở cửa ra vào và cửa sổ để cho gió và ánh nắng tràn ngập căn nhà, giúp không gian sống thông thoáng và hút đi độ ẩm dư thừa trong nhà.
Thường xuyên kiểm tra hệ thống thoát nước và thông gió
Bạn phải luôn kiểm tra xm hệ thống thoát nước và thông gió có đang làm việc hiệu quả hay không để kịp thời phát hiện những trục trặc, ngăn ngừa tắc nghẽn hay rõ rỉ khiến hơi ẩm có cơ hội xâm nhập vào nhà.
Bởi vì các bào từ nấm mốc hiện diện ở khắp mọi nơi, ngay cả những khu vực khô ráo, nên bất cứ lúc nào chúng cũng có thể xâm nhập vào nhà bạn nên bạn cần kiểm tra hệ thóng thoát nước và thông gió thường xuyên.
Lắp đặt các tấm chắn ẩm
Tầng hầm và góc tường là hai khu vực dễ bị ẩm ướt nhất và nấm mốc đen dễ dàng xuất hiện. Vì thế, bạn nên lắp đặt thêm các tấm chắn ẩm và sử dụng các lớp phủ đặc biệt để phòng tránh hơi ẩm từ đất xâm nhập vào không gian.
Bài viết đã gửi đến quý bạn đọc các cách loại bỏ nấm mốc đen đơn giản bằng những nguyên liệu quen thuộc và dễ tìm. Chúc các bạn sẽ thành công loại bỏ nấm mốc đen khỏi nhà mình.